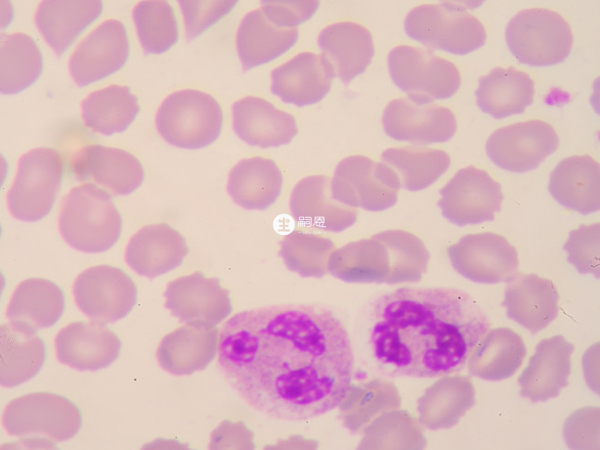

吉赛欣

吉赛欣,即重组人粒细胞刺激因子注射液,为免疫兴奋药,英语治疗癌症化疗等原因导致的中性粒细胞减少症。也可用于促进骨髓移植后的中性粒细胞数升高等。主要有肌肉骨骼和消化系统的不良反应。

吉赛欣说明书
| 通用名称 | 重组人粒细胞刺激因子注射液 | 商品名称 | 吉赛欣 |
| 性状 | 无色透明液体,PH4.0±0.5 | 规格 | 0.6ml:150μg |
| 贮藏 | 密封保存。 | 有效期 | 24个月 |
| 生产企业 | 华北制药金坦生物技术股份有限公司 | 药品价格 | ¥191.00起 |
| 批准文号 | 国药准字S19991017 | 药品类型 | 生物制品 |
吉赛欣作用与功效
- 1. 癌症化疗等原因导致中性粒细胞减少症;癌症患者使用骨髓抑制性化疗药物,特别在强烈的骨髓剥夺性化学药物治疗后,注射本品有助于预防中性粒细胞减少症的发生,减轻中性粒细胞减少的程度,缩短粒细胞缺乏症的持续时间,加速粒细胞数的恢复,从而减少合并感染发热的危险性;
- 2. 促进骨髓移植后的中性粒细胞数升高;
- 3. 骨髓发育不良综合征引起的中性粒细胞减少症,再生障碍性贫血引起的中性粒细胞减少症,先天性、特发性中性粒细胞减少症,骨髓增生异常综合征伴中性粒细胞减少症,周期性中性粒细胞减少症。
吉赛欣的用法用量
肿瘤
用于化疗所致的中性粒细胞减少症等。成年患者化疗后,中性粒细胞数降至1000/mm3(白细胞计数2000/mm3)以下者,在开始化疗后2~5μg/kg,每日1次皮下或静脉注射给药。儿童患者化疗后中性粒细胞数降至500/ mm3(白细胞计数1000/mm3)以下者,在开始化疗后2~5μg/kg,每日1次皮下或静脉注射给药。当中性粒细胞数回升至5000/ mm3(白细胞计数10000/mm3)以上时,停止给药。
急性白血病化疗所致的中性粒细胞减少症
白血病患者化疗后白细胞计数不足1000/mm3,骨髓中的原粒细胞明显减少,外周血液中未见原粒细胞的情况下,成年患者2~5μg/kg每日1次皮下或静脉注射给药;儿童患者2μg/kg每日1次皮下或静脉注射给药。当中性粒细胞数回升至5000/mm3(白细胞计数10000/mm3)以上时,停止给药。
骨髓增生异常综合征伴中性粒细胞减少症
成年患者在其中性粒细胞不足1000/mm3时,2~5μg/kg每日1次皮下或脉注射给药。中性粒细胞数回升至5000/ mm3以上时,停止给药。
再生障碍性贫血所致中性粒细胞减少
成年患者在其中性粒细胞低于1000/mm3时,2~5μg/kg每日1次皮下或静脉注射给药。中性粒细胞数回升至5000/ mm3以上时,酌情减量或停止给药。
周期性中性粒细胞减少症、自身免疫性中性粒细胞减少症和慢性中性粒细胞减少症
成年患者中性粒细胞低于1000/mm3时,1μg/kg每日1次皮下或静脉注射给药。儿童患者中性粒细胞低于1000/mm3时,1μg/kg每日1次皮下或静脉注射给药。中性粒细胞数回升至5000/ mm3以上时,酌情减量或停止给药。
用于促进骨髓移植患者中性粒细胞增加
成人在骨髓移植的第2日至第5日开始用药,2~5μg/kg每日1次皮下或静脉注射给药。儿童在骨髓移植的第2日至第5日开始用药,2μg/kg每日1次皮下或静脉注射给药。中性粒细胞回升至5000/ mm3(白细胞计数10000/mm3)以上时,停止给药。

吉赛欣的不良反应
- 1. 肌肉骨骼系统:有时会有肌肉酸痛、骨痛、腰痛、胸痛的现象;
- 2. 消化系统:有时会出现食欲不振的现象,或肝脏谷丙转氨酶、谷草转氨酶升高;
- 3. 其他:有人会出现发热、头疼、乏力及皮疹,ALP、LDH升高;
- 4. 极少数人会出现休克、间质性肺炎、成人呼吸窘迫综合征、幼稚细胞增加。
吉赛欣的禁忌
- 1. 对本药或其他粒细胞刺激因子过敏者;
- 2. 骨髓中幼稚粒细胞未充分减少的髓性白血病及外周血中存在骨髓幼稚粒细胞的髓性白血病患者。
特殊人群用药
孕妇及哺乳期妇女用药:
不宜用于妊娠或可能怀孕的妇女(妊娠中的用药安全性尚未确定)。
儿童用药:
- 1. 对早产儿、新生儿及婴幼儿用药的安全性尚未确定,建议不用该药(使用经验较少);
- 2. 儿童用药时应密切观察﹑慎重用药。

老人用药:
通常老年患者的生理机能(造血机能﹑肝﹑肾功能)低下,注意用量及用药间隔时间﹑观察患者状态,慎重给药。
使用吉赛欣应在医师指导下使用,并且必须由专业医护人员注射;使用吉赛欣过程中需要每周检查两次血常规;老年患者的生理机能比较低下,用药期间需要特别注意;用药期间注意监测药物不良反应,任何严重、持续或进展性情况均须及时与医生沟通。
四代试管
卵巢早衰交流群三代试管
优生优育攻略群高龄生子
绝经助孕攻略群无精/死精
显微取精交流群冷冻卵子
生育力保存经验群出国生子
海外试管交流群看了又看